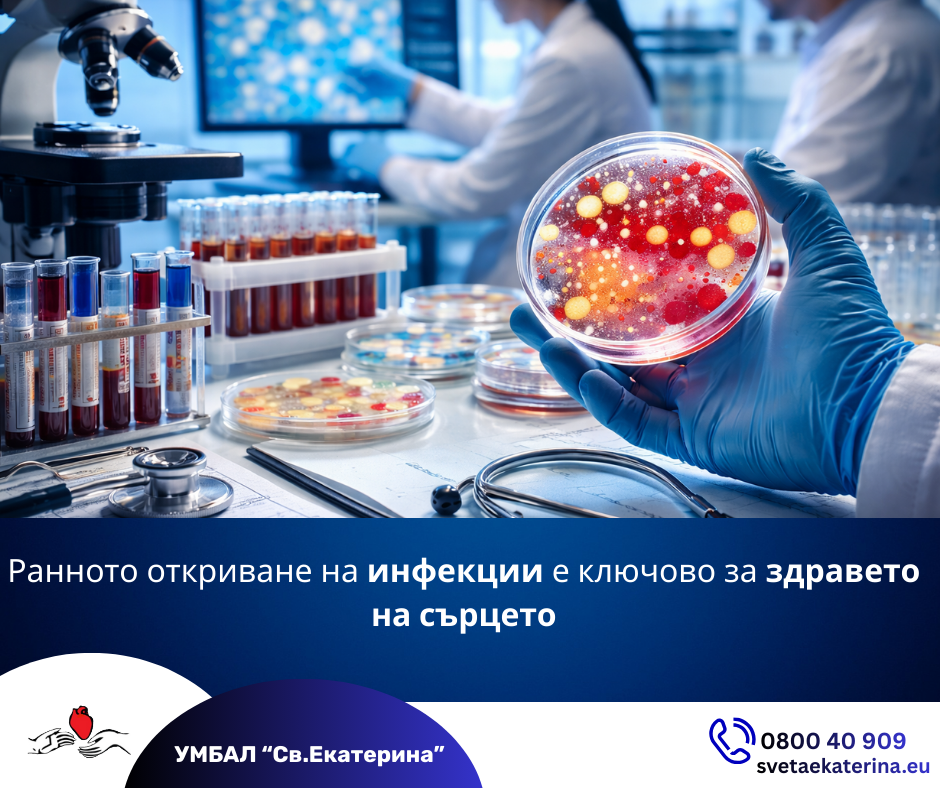

При сърдечносъдовите заболявания навременното откриване на инфекциозни причинители е от решаващо значение за правилната диагноза, ефективното лечение и безопасното протичане на терапията.
В УМБАЛ „Св. Екатерина“ микробиологичните изследвания заемат ключово място в грижата за пациентите. Чрез прилагането на съвременни диагностични технологии и високоспециализирана апаратура, лабораторията осигурява бързи, прецизни и надеждни резултати, които позволяват инфекциите да бъдат разпознати още в ранен етап – преди да доведат до сериозни усложнения.
Микробиологичната диагностика има съществена роля при идентифицирането на инфекции, които могат да причинят или утежнят сърдечни състояния като миокардит и ендокардит. Чрез изследване за бактерии, вируси и други патогени в кръвта се осигурява основата за целенасочено и адекватно лечение.
Изследванията са особено важни и за ранното установяване на нозокомиални инфекции – включително катетър-асоцииран сепсис, пневмония, свързана с интубация, инфекции на хирургичното място и други усложнения, при които бързата реакция е критична. Навременната микробиологична диагностика позволява прецизен избор на антибиотична или антивирусна терапия и значително намалява риска от тежки последици.
Провеждането на микробиологични изследвания се налага при съмнение за инфекциозна причина за симптоми като задух, болка в гърдите, повишена температура, ускорено сърцебиене, както и преди сърдечни операции или при пациенти с изкуствени клапи и импланти.
Екипът на микробиологичната лаборатория на УМБАЛ „Св. Екатерина“ е съставен от висококвалифицирани специалисти с богат опит, които работят в тясно сътрудничество с клиничните екипи, за да гарантират сигурност, проследимост и най-доброто възможно лечение за всеки пациент.